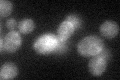
YDL095W
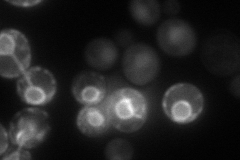
YDL095W
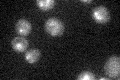
YDL095W

View description
Protein O-mannosyltransferase, transfers mannose residues from dolichyl phosphate-D-mannose to protein serine/threonine residues; one of seven related proteins involved in O-glycosylation which is essential for cell wall rigidity
Localization:
Intensity:
Fold change:
Significance:
-
C’ GFP library in SD
ER26.38 -
N' NOP1pr-GFP in SD
ER71.9001 -
N' TEF2pr-mCherry in SD

cytosol,ER79.7724 -
N' NATIVEpr-GFP in SD

nucleus38.8293 -
N' TEF2pr-VC and Cyto-VN in SD

ER39.95 -
C’ GFP library in SD+DTT

ERN/AN/ANo -
C’ GFP library in SD+H2O2

ER22.050.83No -
C’ GFP library in Starvation Media
ER21.160.8No -
C’ GFP library on the background of Pup2-DaMP

ER -
C’ GFP library on the background of CCT mutant

ER18.84760.714332No
